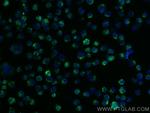
TRIM17 Antibody in Immunocytochemistry (ICC/IF)

Search
Proteintech
TRIM17 Polyclonal Antibody
{{$productOrderCtrl.translations['antibody.pdp.commerceCard.promotion.promotions']}}
{{$productOrderCtrl.translations['antibody.pdp.commerceCard.promotion.viewpromo']}}
{{$productOrderCtrl.translations['antibody.pdp.commerceCard.promotion.promocode']}}: {{promo.promoCode}} {{promo.promoTitle}} {{promo.promoDescription}}. {{$productOrderCtrl.translations['antibody.pdp.commerceCard.promotion.learnmore']}}
产品信息
13663-1-AP
种属反应
宿主/亚型
分类
类型
抗原
偶联物
形式
浓度
规格
纯化类型
保存液
内含物
保存条件
运输条件
产品详细信息
Immunogen sequence: KVKERRERI VLEFEKMNLY LVEEEQRLLQ ALETEEEETA SRLRESVACL DRQGHSLELL LLQLEERSTQ GPLQMLQDMK EPLSRKNNVS VQCPEVAPPT RPRTVCRVPG QIEVLRGFLE DVVPDATSAY PYLLLYESRQ RRYLGSSPEG SGFCSKDRFV AYPCAVGQTA FSSGRHYWEV GMNITGDALW ALGVCRDNVS RKDRVPKCPE NGFWVVQLSK GTKYLSTFSA LTPVMLMEPP SHMGIFLDFE AGEVSFYSVS DGSHLHTYSQ ATFPGPLQPF FCLGAPKSGQ MVISTVTMWV KG (177-477 aa encoded by BC033788)
靶标信息
The protein encoded by this gene is a member of the tripartite motif (TRIM) family. The TRIM motif includes three zinc-binding domains, a RING, a B-box type 1 and a B-box type 2, and a coiled-coil region. The protein localizes to cytoplasmic bodies. The protein is expressed almost exclusively in the testis, but its function is unknown. Multiple alternatively spliced transcript variants have been found for this gene.
仅用于科研。不用于诊断过程。未经明确授权不得转售。
篇参考文献 (0)
生物信息学
蛋白别名: E3 ubiquitin-protein ligase TRIM17; RING finger protein 16; RING finger protein terf; RING finger-B box-coiled coil (RBCC) family member; RING-type E3 ubiquitin transferase TRIM17; Testis RING finger protein; tripartite motif protein 17; tripartite motif protein TRIM17; Tripartite motif-containing protein 17; unnamed protein product
基因别名: RBCC; RNF16; TERF; TRIM17
UniProt ID: (Human) Q9Y577, (Rat) Q9WV59, (Mouse) Q7TPM3
Entrez Gene ID: (Human) 51127, (Rat) 64702, (Mouse) 56631